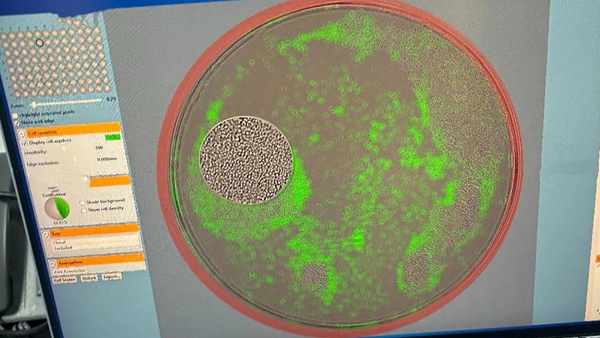
ҵһߣɸѡһϸõƣһѻ֢ԭҩβ

-
【阜成门外】张玉来:日本经济“六季度首负”
日本GDP下滑的主要原因是受到美国关税战的严重冲击,但愈加严峻的通胀形势也暴露出日本经济的衰退迹象。短期......
2025-11-18 17:17:56 -
白雪:美国政府停摆告一段落,市场不确定性尚
根据美国国会预算办公室(CBO)估计,本次停摆将造成约110亿美元的经济活动永久性损失,四季度GDP增速可能被拉......
2025-11-13 13:23:48 -
薛洪言:4000点后将现“慢牛震荡上行”,重点
产业层面,中国经济正呈现多元创新格局,在新能源、创新药、人工智能等领域涌现出一批具备全球竞争力的企业......
2025-11-12 16:09:42 -
房贷利率与理财收益倒挂,是否应提前还贷?
(宋亚芬)央行11日发布的《2025年第三季度中国货币政策执行报告》显示,截至9月末,个人住房贷款加权平均利率......
2025-11-12 16:07:49 -
冯琳:CPI时隔多月重回正增长释放什么信号?
10月份CPI环比上涨0.2%,表现高于季节性水平,加之去年同期价格基数较低,共同推动CPI同比转正,超出市场普......
2025-11-10 15:12:23 -
探店1天|凌晨四点,一群外国人在机场排队等什
(郑艺佳)人来人往的北京首都机场3号航站楼国际到达大厅,是许多外国游客来华的“第一站”。近日,中新经纬走......
2025-11-08 10:35:18 -
品牌大咖说 | 商超店缩减之后:新能源汽车品牌
中国汽车流通协会副秘书长郎学红在接受中新经纬采访时表示:“这一趋势其实在2024年就已经显现。收缩商超店......
2025-11-07 17:31:29 -
产业一线|精神血条拉满!电竞如何为城市文化
” CAC 2025现场 中新经纬董文博 摄 谈及对电竞产业的持续投入,顾黎明表示,“主要是看到它的未来。......
2025-10-29 18:05:26 -
张凌燕:“十五五”时期AI+机器人融合将成产业
放眼全球,与国际机器人“四大家族”——发那科、ABB、安川、库卡相比,中国本土头部企业正逐步形成差异化优......
2025-10-24 16:20:18

言












